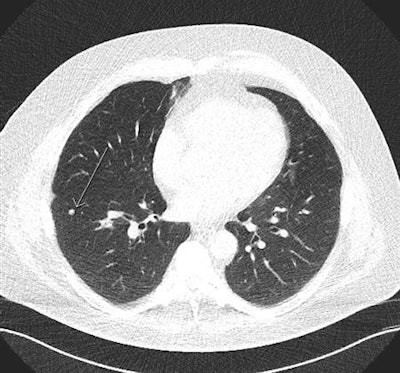

A Swiss modeling study has shown that a national low-dose CT (LDCT) screening program for lung cancer can be cost-effective. The study, published in the July issue of Lung Cancer, sought to clarify the impact of screening across a high-income population with high smoking prevalence and revealed it may reduce lung cancer mortality by 6% to 15%.
Uncertainty about the potential effects and cost-effectiveness of LDCT for lung cancer in Europe, as well as the applicability of results of North American studies, necessitate country-specific studies, according to the authors (Lung Cancer, July 2018, Vol. 121, pp. 61-69).
CT screening has been implemented in North America but not in Europe, though a recent European position statement recommended that planning for the implementation of LDCT screening should start as soon as possible. Any related steps in Switzerland require careful preanalysis and caution, but the study team, led by research scientist Yuki Tomonaga from the Epidemiology, Biostatistics and Prevention Institute (EBPI) at the University of Zurich in Switzerland, hopes the work will help policymakers, payors, and guideline developers who face the decision of whether or not to implement LDCT screening.
The key findings of the study were the following:
- Lung cancer screening may be cost-effective in European Union (EU) countries with a high smoking prevalence.
- The most promising screening scenarios reduced lung cancer mortality by 6% to 15%.
- Systematic screening may increase the number of diagnosed lung cancers by 2% to 6%.
- The most cost-effective annual screening scenarios included heavy smokers ages 60 to 80.
One of the more common arguments to carefully evaluate the introduction of screening in Europe is the fact the population characteristics (age, smoking prevalence, cancer prevalence, survival rate, etc.) are different compared with those of the U.S., which is likely to influence the effectiveness of screening, the authors noted. The best way to investigate whether screening may be cost-effective in a specific country with its specific context is through modeling, which includes country-specific data to allow for many different scenarios.
Study design
The researchers first modeled the natural history of lung cancer and the potential impact of LDCT screening compared with no screening for a simulated Swiss cohort born between 1935 and 1965: They adapted the Microsimulation Screening Analysis-Lung (MISCAN) model using country-specific input parameters regarding population structure, overall survival, lung cancer incidence, histology, mortality, survival, smoking behaviors, and treatment costs.

They examined the effects and costs of 648 screening scenarios with different screening start and stop ages, smoking eligibility criteria, and screening intervals from a public healthcare system perspective across a lifetime horizon in the simulated cohort.
The idea was first to have a model that represented reality as closely as possible, the authors noted, and then, in a second step, implement the potential effects of LDCT to evaluate what happens with and without screening in terms of population health outcomes and cost.
Clear results
All screening scenarios showed an increase in the total number of detected lung cancer cases and a decrease in lung cancer mortality. In terms of efficiency, 15 of 27 scenarios on the efficiency frontier showed incremental cost-effectiveness ratios (ICER) below 50,000 euros per life year gained. These scenarios reduced lung cancer mortality by 6% to 15%, while increasing incidence of lung cancer diagnoses by 2% to 6%. The results suggested lung cancer screening may be cost-effective in Switzerland, a high-income European country with a high smoking prevalence, according to the authors.
But just how applicable are the findings to other high-income European countries with a high prevalence of smoking?

Talking about applicability to other countries is always exciting but complicated, according to co-author Dr. Thomas Frauenfelder, a chest radiologist and vice chair at the Institute of Diagnostic and Interventional Radiology at the University Hospital of Zurich.
"If one considers the effects of screening on mortality reduction, we expect that the results of our study should be well applicable to other high-income countries with high smoking prevalence such as Germany, France, Italy, Belgium, and the U.K," he noted.
Healthcare costs in Switzerland are relatively high compared with many other countries, he pointed out. The cost-effectiveness of a screening program will, therefore, change according to different costs per CT screening or per cancer treatment. Furthermore, the structure of the healthcare systems in terms of the number of potential screening centers with adequate equipment and expertise should also be considered when considering the feasibility of implementation.
The author group underlined some limitations to the study: The cost assessment did not include indirect costs related to work loss and reduced productivity. A considerable proportion of lung cancer cases occur in the working population, according to Frauenfelder, and early detection through screening with a higher probability of remission and cure may lead to a reduction of these indirect costs and an additional benefit at the societal level.
In addition, while the model structure allowed a distinction between initial, continued, and terminal care, it was not possible to differentiate between tumor-free continued care and continued care in case of relapse or metastasis, which may have affected the precision of cost and ICER estimates.
Importantly, the National Lung Screening Trial (NLST) data from the U.S. that the researchers used to estimate the probability of false-positive results and follow-up procedures had a relatively high number of false-positive results (23.3%). These led to additional procedures in 90.4% of all positive screens. However, recent studies based on the Dutch-Belgian Randomized Lung Cancer Screening (NELSON) trial suggest it may be possible to reduce the false-positive rate and the number of unnecessary follow-up procedures by applying refined screening algorithms.
The authors also stressed that better risk stratification before initiation and after obtaining screening results and management of lung cancer patients should improve the cost-effectiveness of screening programs, but they may also have effects on population health. For example, in a scenario in which only very high-risk people would be targeted, the screening would be very cost-effective, but the number of people screened may be so low that it has little or no impact at a population level.
Finally, the model did not factor in the potential introduction of smoking-cessation interventions as part of a screening program. These interventions are likely to increase the cost-effectiveness of screening, according to Frauenfelder.
"The team is now considering investigating alternative screening scenarios, such as with other inclusion criteria or different screening intervals," he said. "We would also like to investigate the potential effects of preventive interventions on a population or individual level."